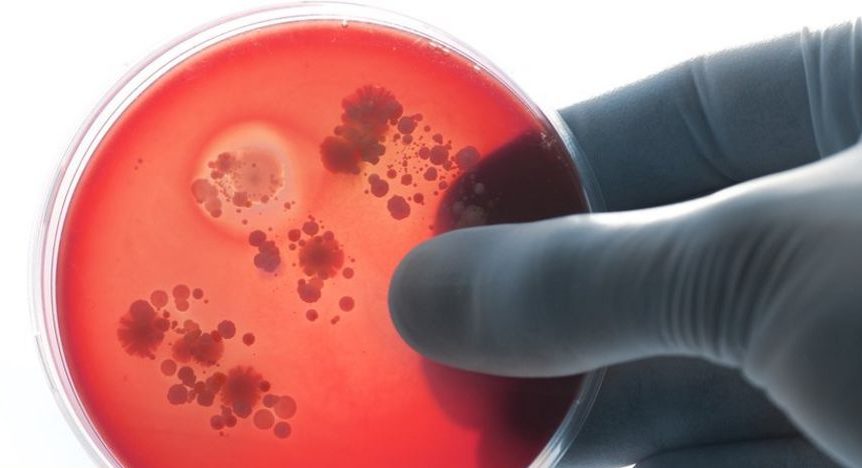

Quarta-feira, 10 de junho de 2026

Por Redação Rádio Caiçara | 3 de outubro de 2022
A meningite é uma doença que pode ser confundida com a gripe, mas as sequelas são graves e ela pode até matar. Neste ano, a capital paulista registrou 56 casos da doença até terça-feira (27), mas nos últimos 90 dias um surto foi identificado, especialmente da meningite meningocócica (causada por bactérias).
Segundo a Secretaria Municipal da Saúde, a doença foi responsável por cinco casos no período de 16 de julho a 15 de setembro. Mas o que causa esse tipo de meningite, como ela é transmitida e de que forma podemos nos proteger?
1) O que é a meningite?
As meninges são as membranas que envolvem todo o sistema nervoso central. A meningite ocorre quando há alguma inflamação desse revestimento, causado por micro-organismos, alergias a medicamentos, câncer e outros agentes.
“A meningite é a inflamação das membranas que cobrem o cérebro, essas ‘capinhas’. Por isso, essa inflamação ocasiona dor de cabeça, fadiga, mal-estar, febre alta, rigidez de nuca…”, explica Lina Paola Rodrigues, infectologista da BP – A Beneficência Portuguesa de São Paulo.
A meningite tem uma alta taxa de mortalidade e sequelas, como surdez, perda dos movimentos e danos ao sistema nervoso. As crianças são a faixa etária mais atingida, e os pacientes devem ter um acompanhamento por pelo menos 6 meses depois da doença.
2) O que causa a doença?
A doença pode ser causada por bactérias, vírus, fungos e parasitas, segundo o Ministério da Saúde.
Segundo a pasta, as meningites virais e bacterianas são as mais importantes para a saúde pública, devido a magnitude de sua ocorrência e o potencial de produzir surtos.
O ministério ressalta ainda que a ocorrência das meningites bacterianas é mais comum no outono-inverno e das virais na primavera-verão. O sexo masculino também é o mais acometido pela doença.
3) O que é a meningite meningocócica ?
A meningite pode ser causada por várias bactérias, mas as principais são: meningococo e pneumococo.
A meningite meningocócica em específico é causada pelos meningococos Neisseria meningitidis e pode afetar pessoas de qualquer idade.
4) Como ocorre a transmissão da meningite meningocócica?
A meningite é transmitida quando pequenas gotas de saliva da pessoa infectada entram em contato com as mucosas do nariz ou da boca de um indivíduo saudável. Pode ser por meio de tosse, espirro ou secreções eliminadas pelo trato respiratório (nariz e boca).
Segundo a Secretaria Municipal de Saúde de São Paulo, para que essa transmissão ocorra, há necessidade de contato direto, íntimo e frequente com a pessoa doente (troca de secreção).
5) Quais são os sintomas da meningite meningocócica?
Os principais sintomas de meningites bacterianas costumam aparecer em pouco tempo. São eles, ainda de acordo com o Ministério da Saúde: Febre alta; Mal-estar; Vômitos; Dor forte de cabeça e no pescoço; Dificuldade para encostar o queixo no peito; Manchas vermelhas espalhadas pelo corpo (em alguns casos).
Além disso, nos bebês, os seguintes sintomas são mais comuns: Moleira tensa ou elevada; Gemido quando tocado; Inquietação com choro agudo; Rigidez corporal com movimentos involuntários, ou corpo “mole”, largado.
6) Quais são as formas de prevenção?
Existem imunizantes no sistema público de saúde que protegem contra a doença. As vacinas disponíveis no calendário de vacinação do Programa Nacional de Imunização são:
Vacina meningocócica (Conjugada): protege contra a doença meningocócica causada pelo sorogrupo C.
Vacina pneumocócica 10-valente (conjugada): protege contra as doenças invasivas causadas pelo Streptococcus pneumoniae, incluindo meningite.
Pentavalente: protege contra as doenças invasivas causadas pelo Haemophilus influenzae sorotipo B, como meningite, e também contra a difteria, tétano, coqueluche e hepatite B.
7) Como é o tratamento da meningite?
O tratamento depende do agente causador da infecção.
A meningite viral não tem tratamento específico e, como outras viroses, resolve-se por conta própria. Os medicamentos só podem tratar os sintomas, como dor e febre, explica o Ministério da Saúde.
Já as meningites bacterianas são mais graves e devem ser tratadas imediatamente, em ambiente hospitalar, com administração de antibióticos.
De acordo com a Secretaria de Saúde de São Paulo, após 24 horas do início do tratamento com antibiótico, o paciente não transmite mais a bactéria.





Os comentários estão desativados.